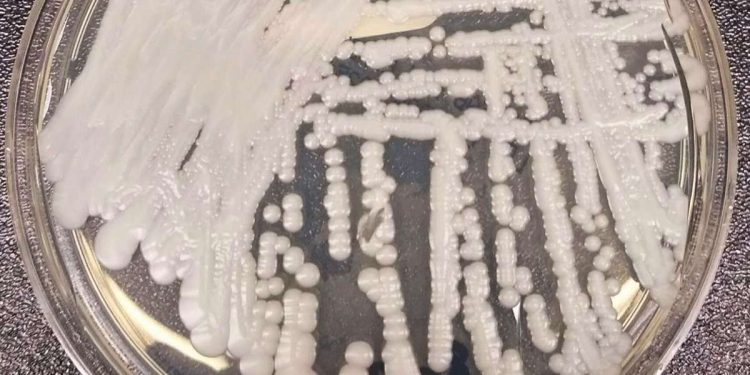
candida auris

La Candida Auris minaccia l’essere umano: si tratta di un fungo, diffuso in 50 Paesi, che ha una mortalità che va dal 30% al 70%. Uno studio della Johns Hopkins Bloomberg School of Public Health, i cui risultati sono stati pubblicati sulla rivista mBio, dimostra che la sua propagazione viene favorita dalle alte temperature. Il riscaldamento globale, dunque, è una delle cause.
Il fungo ha infatti una notevole capacità di adattamento al calore, a differenza di altri geneticamente simili che invece non sopravvivono alle elevate temperature. Ne è una dimostrazione il fatto che la possibilità di infettare l’uomo sia emersa contemporaneamente in tre continenti, ovvero America, Africa e Asia, in ceppi distinti tra loro. Ma non è tutto. Gli scienziati della McMaster University hanno scoperto infatti anche che riesce a sviluppare facilmente una resistenza ai farmaci generando sempre nuove varianti. È per questo motivo che gli antisettici comuni non sono efficaci su di esso.
Candida Auris cos’è: fungo si propaga con riscaldamento globale. Anche in Italia
La Candida Auris, il fungo killer che si propaga più facilmente a causa del riscaldamento globale, è diffuso in tutto il mondo. La prima volta, come riportato dal Corriere della Sera, è stato isolato nel 2009 in Giappone e proveniva dall’orecchio di una donna. Il primo esemplare noto, però, risale al 1996 in Corea. I primi focolai europei si sono verificati a partire dalla primavera del 2015 in Francia. In Italia il primo caso è stato registrato nel 2019 in Liguria. Adesso è tornato a spaventare il Paese. A Mestre, nelle scorse ore, è stato isolato su un paziente ricoverato che pare averlo contratto all’estero. Per tutti gli altri è scattato il tampone.
Gli esperti dunque intendono ora monitorare la situazione. Il fungo è molto contagioso e nel caso in cui le persone che lo hanno contratto non si curino con una terapia adeguata e nei tempi prestabiliti, le conseguenze possono essere molto gravi. La mortalità va dal 30% al 70%.